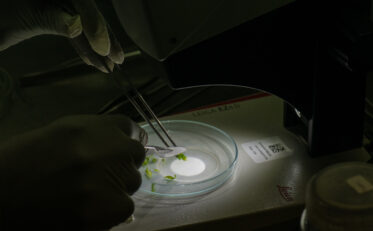
Meristem tips are carefully cut from thermotherapy-treated shoots using a microscope. Photo: Michael Major/Crop Trust

The last time I saw Morag Ferguson I was shoving hummus into my mouth and washing it down with arak. It’s been 25 years since Morag and I worked in Syria. The times have changed, but not Morag.
I caught up with Morag at her home for the past 15 years – Nairobi, Kenya. Morag now works for the International Institute of Tropical Agriculture and she’s doing some mighty fascinating work with cassava. Morag took my Crop Trust colleague, Benjamin Kilian, and me, out to her second home at KEPHIS, which is a Kenyan institute that makes sure plants and seeds are free of disease, insects, nematodes and other nasties.
Morag’s team is trying to eliminate some viruses which are prevalent in cassava in Eastern Africa so that they can transport the germplasm to Western Africa to be safeguarded. Cassava is a hugely important food crop in Africa and it’s hugely important that the genetic diversity of cassava is safeguarded.
So it was really cool today to see my old friend, Morag, working so passionately to ensure the future of cassava is secure.